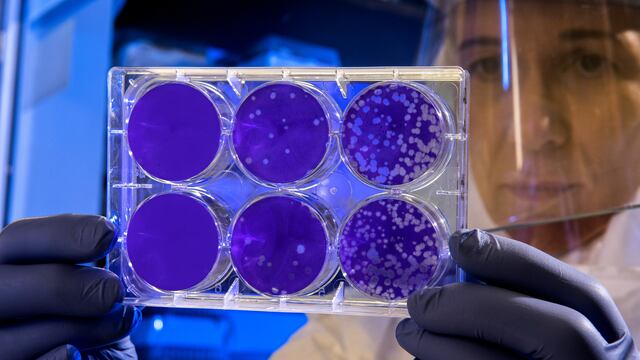
Virus

Científicos de Francia y de Brasil descubrieron un nuevo virus de ameba que los ha impactado por ser completamente diferente a cualquier otro que se haya conocido.
Se trata del Yaravirus, que debe su nombre a la mitología brasileña y cuyo ADN está compuesto hasta en un 90 por ciento de genes desconocidos, ante lo cual, sus descubridores afirman:
El Yaravirus es "un nuevo linaje de virus amebianos con un desconcertante origen y filogenia"
Autores del estudio
Sólo seis genes del Yaravirus estarían relacionados con otros virus
En un artículo preimpreso, virólogos de la Universidad de Aix-Marseille en Francia y de la Universidad Federal de Minas Gerais de Brasil, señalaron que el nuevo virus fue encontrado en el lago Pampulha, de la ciudad brasileña de Belo Horizonte.
Para conocer sus orígenes, los investigadores examinaron la base de datos pública de ocho mil 535 metagenomas.
Sin embargo, los expertos se llevaron una gran sorpresa cuando los resultados les indicaron que hasta el momento no existe otro organismo similar, ya que solo 6 de sus genes parecen estar relacionados lejanamente con homólogos conocidos.
Ante ello, los virólogos y autores del estudio, Bernard La Scola de la Universidad de Aix-Marseille en Francia y Jônatas S. Abrahão de la Universidad Federal de Minas Gerais de Brasil, señalaron:
Si bien "se ha visto que la mayoría de los virus conocidos de amebas comparten muchas características que eventualmente llevaron a los autores a clasificarlos en grupos evolutivos comunes… [Yaravirus es] un nuevo linaje de virus amebianos con un desconcertante origen y filogenia "
Autores del estudio
El Yaravirus es solo es el último virus misterioso que se ha descubierto
Los investigadores afirman que el Yaravirus es solo uno más de los misteriosos virus que han descubierto.
El año pasado encontraron un par de virus gigantes (otros dos valores atípicos virales) que nombraron como Tupanvirus soda lake y Tupanvirus deep ocean, cada uno en referencia a los ambientes acuáticos extremos en los que se encontraron.